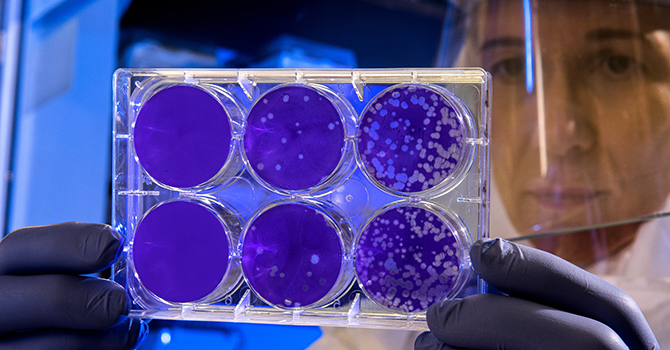
Scientist in a CDC lab examines the result of a plaque assay.

A COVID-19 Vaccine Needs the Public's Trust--And It's Risky to Cut Corners on Clinical Trials, as Russia Is
Abram L. Wagner
On August 11, Russian President Vladimir Putin announced that a coronavirus vaccine developed in the country has been registered for use. Why is this news being condemned broadly by scientists around the world?